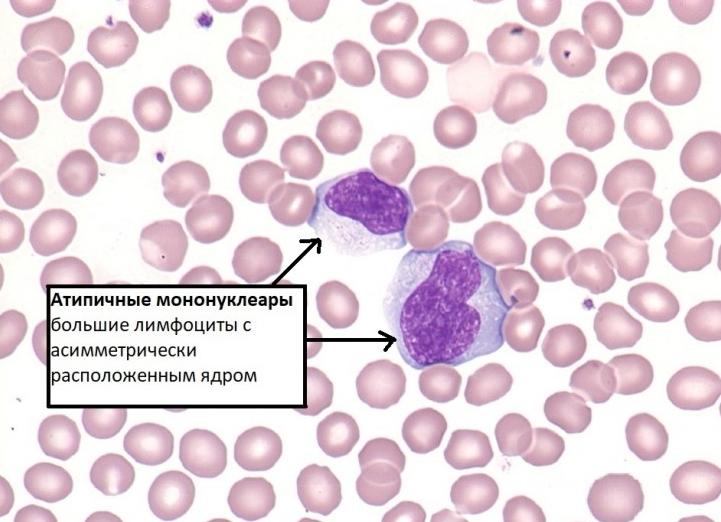
Мононуклеары в крови

в какой воде растворять монурал [stextbox id=’info’ caption=’ДЕШЕВЫЕ ЛЕКАРСТВА ОТ ГЕПАТИТА С’]Сотни...
Применение Монурала у кошек при цистите Цистит – довольно распространенная болезнь среди...
Ответы@Mail.Ru: Кто знает, как принимать монурал? Описание лекарственной формы: белый гранулированный порошок...
Монурал 2 или 3 грамма разница — Все про почки Монурал –...
Монозиготные близнецы Зачатие и рождения ребенка – это великое чудо, которого многие...
Мононуклеары в крови, их виды и значение : В кровеносной системе циркулирует...
Атипичные мононуклеары в крови у ребенка: норма Содержание Одноядерные клетки называются мононуклеары,...
Что показывают атипичные мононуклеары в крови Что показывают атипичные мононуклеары в крови?...
Монохориальная диамниотическая двойня: близнецы и их вынашивание Рождение близнецов случается тогда, когда...
Монохориальная двойня – высокий риск для мамы и малышей Одна плацента на...